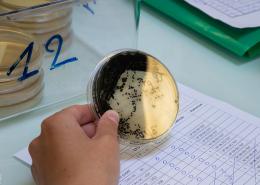

Le Laboratoire Départemental d’Analyses, LDA33, est un service public dédié à la protection des populations à la sécurité alimentaire, à la sécurité sanitaire des eaux, à la santé animale et végétale.
Le LDA33 s'intègre donc dans le concept « One Health, une seule santé pour tous » en défendant la santé à l'interface de celle des hommes, des animaux, des végétaux et de leur environnement.
Ce service de 50 agents aux métiers très spécifiques : techniciens de laboratoire, préleveurs, responsable métrologie, responsable qualité..., produit une moyenne de 350 000 analyses par an. Lors des périodes de contrôles plus intensifs, le LDA33 voit son personnel s’étoffer d’une équipe de préleveurs dépêchés en renfort (contrôle des eaux de baignade) et de polyvalences pour les campagnes de prophylaxie et de surveillance des organismes réglementés en santé végétale. Le Laboratoire Départemental d’Analyses doit garantir l’absence de tout risque pour la population girondine.
En 2024, une surveillance accrue de la production ostréicole a généré des prélèvements et analyses hebdomadaires renforcés de janvier à avril 2024. Le contrôle sanitaire des eaux effectués pour l'ARS en 2024 à permis de surveiller 5 000 échantillons d'eau destinée à la consommation humaine de la production à la distribution, 2 500 échantillons d'eaux de piscine baignade et 800 échantillons d'eaux de baignade.